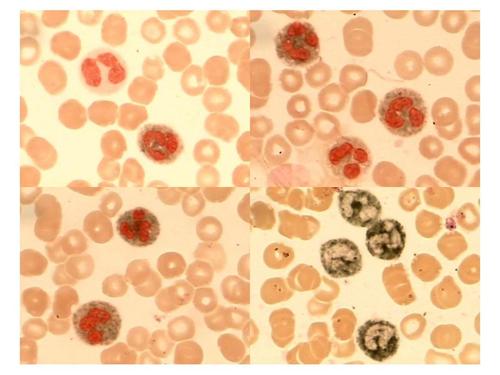
\

SCI论文(www.lunwensci.com):
摘要:教学内容、教学方式的改革是当今高等教育教学改革的核心。《组织与细胞化学》实验技术与方法在生命科学领域中应用广泛,为本科生开设的一门重要的课程。为培养具有创新能力、适应现代社会的复合型人才,我们对《组织与细胞化学》的教学内容、教学方法、教学手段等进行了探索性的改革与实践,并取得一定成效。
关键词:组织与细胞化学;教学改革;本科生
本文引用格式:范丽华,等.本科生《组织与细胞化学》教学改革浅析[J].教育现代化,2019,6(82):83-84.
《组织与细胞化学》是我们教研室面向四年制大四本科生开设的一门课程,该课程具有实验技术很强的特点,其中免疫组化技术手段在生命科学研究及医学领域中应用广泛,针对大四学生马上要进入研究生阶段的学习的特点,我们学院开设该课程,意在通过该课程的学习,使学生能够快速进入研究生阶段的课题研究状态。近年来,随着科技水平的快速发展及高尖端仪器的不断问世,组织与细胞化学技术也取得了日新月益的变化,传统意义上的组织化学中许多经典的实验逐渐被新的实验技术、新的实验理论所取代,现代组织化学内容亦应运而生。这就要求教师在教学过程中,尽可能多地增加现代组织化学的技术理论,并结合科研前沿进展,开拓学生的视野,不断探索出新的教学方法及教学模式[1]。在以往的“填鸭式”教育模式中,学生通常处于“被动学”的状态,不利于激发学生的创新性思维。我们通过PBL教学模式在该课程中的应用,发现能够充分调动学生的学习兴趣,并能够提高学生独立分析问题及解决问题的能力,有助于培养学生的创新性思维。本科生教育是促进学科建设和人才培养的重要途径,怎样把本科生培养成有创新能力的合格人才,是我们教师肩负的重任。为顺应时代发展的趋势,我们对该门课程做了以下改革。
一 改革课程内容的设置
在课程内容的设置方面,我们根据本课程实验性强的特点,力求缩短理论教学时间,加大实验操作比重[2]。使学生掌握并能熟练运用组织与细胞化学的实验方法,课程结束时能够设计出一项与课程相关的实验项目。在理论教学内容方面选取组织化学研究的一些方法和技术作为教学重点,主要包括酶组织化学、免疫组织化学技术、原位杂交组织化学、组织和细胞培养技术、细胞凋亡及显微摄影技术,重点讲授免疫组织化学技术的原理、方法。实验内容我们除了开设一些验证性的实验,还增加了培养学生创造性思维的设计性实验。我们不仅开设了一般组织化学中一些酶的显示实验,如过氧化氢酶的显示。同时还增加了在科研中应用广泛的免疫组织化学综合性实验,为学生进入研究生阶段的个人研究打下良好的基础。我们还将部分应用组织与细胞化学实验技术的最新科研文献作为教学内容,使学生能更好的了解科研前沿及动态,真正致力于实践与理论相结合,开阔学生视野。
二改革教学模式,采用PBL教学模式培养学生的创新能力
PBL(Problem-Based Learning)教学模式于20世纪60年代由加拿大麦克马斯特大学首创,最早应用于医学类院校。在我国最早是由原西安医科大学和上海第二医科大学于1986年将PBL教学模式引进至课程中[3]。该模式强调以学生的自主学习为主,通过教师设置问题,使学生在致力于问题的解决中,通过查阅文献自主获取隐含在问题背后的科学知识。该模式还强调以小组学习为特色,需将学生分成4-6人的学习小组,通过学生的自主探究和合作来解决问题。学生通过以小组形式查阅文献及制作PPT,可以大大提高学习的积极性及效率,并提高分析问题、解决问题的能力及协作学习能力[4]。采用传统的教学方式,对于本门课的教与学的效果十分不理想,鉴于此,采用PBL教学模式培养学生的创新能力以及提升教师自身的素质显得尤为重要。在教学模式及教学方法上,从以往以教师为中心的课堂教学形式,过渡到以学生为中心的自主学习的方式,建立起以老师为主导,以学生为为主体的教学模式[2]。
在实验教学中过去我们给学生开设的实验大多是验证性实验,教师通过讲解实验目的、原理,演示实验操作,学生模仿实验操作,教师总结的实验课模式[5]。
例如上一般细胞化学实验-酸性磷酸酶的显示实验中,老师把实验试剂以及实验条件都预试好了,甚至将鱼血都取好,学生只需按照老师的实验条件去做,都能得到好的实验结果。这种教学模式中学生通常是被动的、处于一种配合教师完成实验教学的心态下完成实验,学习的积极性及兴趣不能充分调动,并不能很好地达到培养创新性人才的目标。因此,我们将PBL模式引入课程中,在教学中通过先设置问题,如“已知某种蛋白质是细胞内的重要组成成分,如何才能确定该蛋白在细胞内的分布?”要求学生根据该门课程中已学习的方法进行设计。将学生分成4人学习小组,进行分工合作学习。不同小组设计出来的方法有多种,有用一般组织化学方法来设计的,也有用免疫组化方法进行设计的,各个小组设计的方法各有特色及亮点。课堂气氛非常活跃,学生踊跃发言,一改以往以教师为主导的课堂沉闷气氛。从而充分调动了学生的学习兴趣及创新能力,也培养了独立思考,分析问题,解决问题的能力。在理论教学中,我们同时将涉及免疫组化技术科研文献作为试点教学内容,并设置问题,布置学生查阅相关文献,从而拓展学生的知识面并使学生能了解最新学术前沿进展。
三 完善教学评估体系
教学考核和评估是教学成效及学情反馈的重要手段。组织与细胞化学技术的学生成绩由平时成绩(20%)、闭卷的理论课期中考试成绩(20%)及期末考试成绩(60%)3部分组成。理论课主要是考核酶组织化学、免疫组织化学技术、原位杂交组织化学、组织和细胞培养技术、细胞凋亡及显微摄影技术章节中原理及方法。平时成绩主要考核PBL教学方法中学生学习效果及课后作业,教师从小组团队组织,文献查阅,小组讨论,ppt制作,成员互助等全方位多角度对小组进行考量[7]。同时从学习态度,参与积极性,解决问题的灵活度等方面对每位同学进行评估[8]。
四 实施教改后的教学成效
我们对13,14级学生实施以上教学改革后,取得了较好的教学效果。与未开展教改的12级学生考试成绩对比,学生成绩有显著提高。对13,14级两个年级学生进行调查研究表明,调查内容包括:教学内容、教学方法满意度、创新性思维能力、学生自主学习能力等。87%的学生认为教学内容合理。教师以实践经验和科研成果作为补充教学内容,课程更加充实[6],学生对教师上课情况满意度达85%。采用PBL教学方法后,学生的学习兴趣得到激发,成员互助及协助能力明显提高,学生的自主学习能力比未开展PBL教学模式的班级明显提高。
以上是我们在《组织与细胞化学》课程教学改革中做的一些有效及有益的尝试,其中还有一些不足之处我们将会继续完善和改进,进而实施本科生教育是促进学科建设和人才培养的重要途径,从而把本科生培养成21世纪具有创新能力的合格人才。
参考文献
[1]王东,李雅娜,时彦,等.研究生《组织化学技术》实验教学的实践和体会[J].西北医学教育,2008,l6(3):455-456.
[2]刘佳梅,陈东,刘颖.研究生免疫组织化学技术教学改革初探[J].山西医科大学学报(基础医学教育版).2007,9(2):119-120.
[3]马志华,张茹英,万宝珍.PBL“以问题为基础”教学方法的发展概况[J].中华护理杂志,1996,31(8):488-491.
[4]乔颖.PBL模式在高校信息素质教育中应用模式的构建研究[J].农业图书情报学刊,2010,22(5):172-173.
[5]李洪安,蒋金芳,李锋,等.《现代组织化学》实验的改革实践[J].农垦医学,2007,29(6):483-484.
[6]穆长征,田鹤,刘霞,等.医学硕士研究生免疫组织化学PBL教学模式改革探索[J].中国组织化学与细胞化学杂志,20(3):291-292.
[7]陈金武,齐璐璐,孙娴.细胞生物学实践教学中PBL模式的应用[J].合肥师范学院学报,2014,32(6):115-125.
[8]汪青.国内医学院校Pbl教学摸式的应用现状及问题剖析[J].复旦教育论坛,2010,8(5):88-91.
关注SCI论文创作发表,寻求SCI论文修改润色、SCI论文代发表等服务支撑,请锁定SCI论文网! 文章出自SCI论文网转载请注明出处:https://www.lunwensci.com/jiaoyulunwen/29299.html